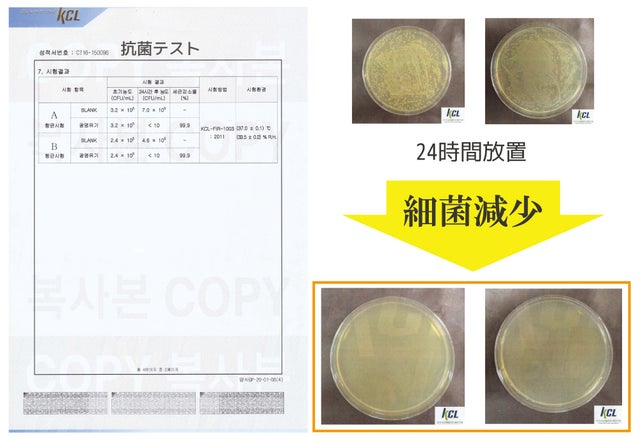

プロジェクト実行者
ストーリー
- 銅78%の合金素材で素早かな伝導率、 優れた抗菌機能!
- 横型のリブがお湯が流れをスムーズにさせて、味や香りを豊かにします!
- 藤原道長の和歌が刻まれた特別な黄銅ドリッパー自分へのご褒美や大切な方に贈り物としてお勧めです!
リターン品の配送が完了するまで、弊社は THE DAWNの日本における独占販売権を有する正規代理店です。詳細に関しては、ページ下部のリスク&チャレンジをご確認ください。



■銅の優れた抗菌作用

銅には昔から抗菌作用があると言われています。
「銅壺(どうこ)の水は腐らない」、「水たまりに銅片を入れるとボウフラが湧かない」という話があるように、金属イオンが抗菌効果があると言われています。
そう考えると、インドで人々が何千年も前から銅のカップで水などを飲んできたのも不思議ではありません。
米国でさえ、飲料水を消費者に運んでいるのは銅管を使っているそうです。
銅は自然に存在し耐食性が高く、抗菌作用がある素材で知られています。

■私たちの身近な銅製品

銅には微量金属作用により細菌のはたらきを抑える効果があり、私たちの身近なところにも様々な形となって利用されています。多くの建物で給水・給湯配管に銅管を使用することで自然に抗菌することができます。


1300℃に達する火炎の中で銅と錫をそれぞれ78%と22%の割合で

正確に混ぜて溶かし、黙々と溶解炉とかまどを行き来する数百回、

一つ一つ丁寧に金づちを使ってこそ、玲瓏たる空色の黄金に輝く黄銅ドリッパーが誕生します。 ※ 実際のガベノッの製造画像

日本の方なら藤原道長の和歌を知らない方は多分いないでしょう。
「この世をば わが世とぞ思う 望月の 欠けたることも なしと思えば」
藤原道長の三女·威子様が嫁いだ時の喜びを詠んだ和歌を黄銅ドリッパーに刻印しました。
平安時代の趣を感じながら、藤原道長と共にするティータイムいかがでしょうか?
自分へのご褒美や大切な方に贈り物としてお勧めです!



ガベノッのドリッパーは、販売されている鉄のドリッパーやプラスチック素材のドリッパーが縦型溝であるのとは異なり、横型の溝を導入しました。

13段階の横型リブは抽出の速度を落とし、コーヒーやお茶に接する面積が広くして豊かで深い味わいができるようにします。


● プラスチックのドリッパー
約100℃のお湯を注いだ後、1回お湯が抜けた後に温度をチェック : 最大 65.2℃

●黄銅ドリッパー
約100℃のお湯を注いだ後、1回お湯が抜けた後に温度をチェック : 最大 73.7℃
黄銅ドリッパーの素早い熱伝導率
ドリッパーの主な素材である銅は、熱伝導率が高いです。
同じ条件でテストを行ったときに、10℃の差があることを分かります。
お湯の温度が97℃に違いほど、コーヒーやお茶の深い味わいを引き出すことができます。
*抽出後はドリッパー本体はかなり熱くなっているので、やけどなどに十分ご注意ください。


黄銅ドリッパーの主成分である銅は、古くから抗菌性が認められてきた素材で、銅自体だけでも抗菌効果があるため、古くから食器として使われてきました。
ガベノッの黄銅ドリッパーは高い抗菌力を持っています。
生活に密接な2種類の細菌の抗菌テストを行った結果、細菌が減少していることが確認できます。


スクラッチに弱いプラスチック素材のドリッパー

落とすと割れてしまう陶器ドリッパー

落としたりぶつけたりしても丈夫な黄銅ドリッパー
1300℃の火馬中で銅と錫を合金して作られた黄銅ドリッパーは強力な耐久性を持っています。
作る過程でも数百回のハンマーを使って鍛えられた黄銅は、強い衝撃でも壊れにくく、長期間変形せずに使用できます。 そのため古い遺物でも形態が保存されており、コインや配管などに使用できます。



■こだわりの麻紙フィルター
麻紙は麻の皮や麻布を切ってすいて製造した紙のことで一般の紙フィルターより水に強く組織が細かいため、 珈琲やお茶の不純物を取り除きます。
※麻紙フィルターの代わりにハリオV60を使用しても構いません。



丈夫で反りや変形がなく、家具などに多く使われるクルミの木でホルダーを製作し、黄銅ドリッパーと共に上品な雰囲気を出しました。


本製品は皆様の安心のためにに有害物質テストを実行しました。
その結果、有害物質は不検出されております。安心してご利用してください。









■焙煎【ロースト】とは、コーヒーの生豆を煎る加熱作業のこと
コーヒーの味わいは、焙煎の度合いによって大きく変化します。
同じコーヒー豆を使っても、煎る時間を短くすると苦みが少なくさっぱりした味わいになり、長くすると苦みとコクが増していきます。


■細かい粒子に粉砕する場合
少し細かくひいた豆の間の空間が少なく、お湯の浸透率を高め、コーヒーの旨味成分をしっかりと抽出することができます。
■大きな粒子に粉砕する場合
大きく粉砕したコーヒー豆は隙間が広くてお湯の流れが速く、さっぱりした酸味を感じることができます。


1.コーヒーを抽出する前にドリッパーの温度を維持するために予熱をします。

2.粉砕したコーヒー豆粉を1杯あたり20g程度入れてください。

3.安定した味わいを抽出するために、コーヒー豆を平たくします。

4.30mlのお湯を注ぎ、30秒間コーヒー豆をふやかします。

5. 30秒経ったら、20mlのお湯を注いで2次抽出してください。
そしてフィルター内の水が10%程度残っている場合、もう一度30mlのお湯を注いで3次抽出を行います。
最後に110mlのお湯を注いで、全部で4次抽出します。

2分前後が最もおいしいコーヒーを抽出できる時間です。
焙煎は中煎りくらいが酸味が出やすく美味しいと言われます。
深煎りだと味が少し重たくなります。麻紙フィルターは紙フィルターに比べて目が粗いのでザラメより少し細かくひいた豆が適しています。
深くて濃い味をご希望の方はそのまま飲んで薄いコーヒーが飲みたい方や、アイスコーヒーが飲みたい方はお好みに合わせてお湯を追加するか、氷を追加して召し上がってください。


様々な種類のお茶も黄銅ドリッパーで美味しく淹れることができます。

お茶の場合は、最初の1回目におろしたお茶は予熱や異物排出のために飲まずに捨ててください。

2回目からゆっくり召し上がってください。

お茶を入れてから3~4回淹れるのが理想的です。

いつでもお好きな場所で、黄銅ドリッパーと一緒にティータイムを楽しんでください。



軽い水染みの場合
乾いた布にケチャップをつけてドリッパーの方向に磨きます。
ケチャップのクエン酸成分が器をきれいにします。洗剤でもう一度洗い、乾いた布で水気を完全に取って保管します。染みがあっても使いながら自然に消えます。
濃い水染みの場合
表面が硬いスポンジを使ってドリッパーのキメで強くこすります。 研磨する過程を数回繰り返すと元の色に戻ります
■使用しない場合の保存方法
使用しない場合は水気を完全に取り除いた後、布や紙に包んで
湿気のない乾燥した場所に保管してください。
*コーヒー抽出後には本体がかなり熱くなっており、直接触るとやけどをする恐れがあります。必ずドリッパーが冷めた後に移動するか、手袋を利用して移動させてください。
*直火、オーブン、電子レンジなどで加熱しないでください。破損、やけどの原因になります。





真鍮ドリッパーは高級パッケージボックスに梱包され出荷されます。

Q.洗浄方法を教えてください。
A 黄銅ドリッパーの特性上、最初は鉄臭がすることがあります。
初回に使用する際は、水とお酢を30:1の割合で混ぜて、30分ほど漬けておきます。 使用中、シミが生じる場合は表面の粗い硬いスポンジを使って拭くとシミが取れます。
Q.キャンプに使用してもいいですか?
A 黄銅ドリッパーは、いつでもどこでも携帯可能で使用できます。
たくさんの方々がキャンプに使用しています。
しかし直接火を加熱するとドリッパーが割れる可能性があります。
又は強い酸性または塩分により変色しやすいので、ご使用の際はご注意ください。
Q.お茶を飲む時に使ってもいいですか?
Aガベノット黄銅ドリッパーはコーヒーはもちろん各種お茶を飲む時にも使えます。ご自由に使用してください。
Q.ホルダーはどこに使用しますか?
A ガベノットの構成品で、クルミの木で作ったホルダーが提供されます。
ホルダーは、カップの入り口に乗せその上に黄銅ドリッパーを載せる際に使用してください。
使用しない時は真鍮ドリッパーの受け皿としても使用できます。
木製ホルダーは水や湿気に弱いので、水がついた場合は乾いたタオルで拭いて涼しいところに保管してください。
Q 麻紙のフィルターを使い終えた後は、どうしますか?
A 黄銅ドリッパーは他のフィルターと兼用してご使用いただけます。 麻紙フィルターに代わってハリオV60を使用してもいいですし、他社のフィルターを利用しても構いません。


『ガベノッ・黄銅ドリッパー 』を製作しましたザ·ダンです。
弊社は韓国2014年度からコーヒー事業を始め、現在は黄銅ドリッパーを開発するまでに至りました。
黄銅という金属素材は温度維持に優れており、コーヒーは温度に敏感なためこれを組み合わせて美味しい味を出す黄銅ドリッパーを作るようになりました。
黄銅は強力な耐久性と銅の優れた抗菌効果があるため、手入れを上手にできれば
10年20年、一生いつまでもおいしいコーヒーを召し上がることができます。
さらに麻紙で作ったフィルターはコーヒー豆の微分をよくろ過し、細かい組織が水の流れる速度を遅くしてくれるので、コーヒーと水を合わせ、深い味を引き出します。
藤原道長の和歌と共に、上品のオブジェとして
自分へのご褒美に、大切な人の贈り物として
黄銅ドリッパーはいかがでしょうか?
皆様、ご支援・応援の程よろしくお願いします。

本製品は韓国よりの配送となります。
日本国内では佐川急便を通じてご支援者にお届けします。
配送後の詳細は活動レポートにて随時お知らせいたします。

正規代理店:セトワークス
・プロジェクトの属性:輸入商品
・代理店によるサポート : 代理店による日本語カスタマー対応、保証(3か月間)
・この商品を輸入しようと思った理由 :黄銅ドリッパーの優れた抗菌力と熱伝達力を 幕明の皆さんにもご紹介したいと思いました。
・プロジェクト実行者(国) : 韓国
・製品者(国) : 韓国
・製造者(国) : 韓国
setoworksは日本の新しい製品を外国にいち早く紹介する事業を始め、海外の新しい商品や直接企画した多様なプロダクト製品を日本国内に紹介する事業を展開しています。たくさんのご支援の程よろしくお願い致します。

リスク&チャレンジ
※使用感などに関しては、感じ方に個人差が予想される商品でございます。そのため、使用感などに関する返品・返金はお受けいたしかねます。 ※初期不良以外に関する返品・返金はお受けいたしかねます。 ※開発中の製品のため、デザイン・カラー・素材などの仕様が一部変更になる可能性がございます。 ※モニター環境によって、画像の色が実物と異なって見えることがございます。 ※応援購入の数が想定を上回った場合、製造工程上の都合などにより出荷時期が遅れる場合がございます。 ※想定を上回る皆様から応援購入をいただき、量産体制をさらに充実させることができた場合、一般販売価格が予定価格を下回る可能性がございます。 ※リターンの配送が完了するまでセトワークスは THE DAWNの日本における独占販売権を有する正規代理店です。並行輸入品が発生する可能性がございますが、並行輸入品には正規代理店による製品サポートを受けることができません。 また、正規代理店を通じて購入することで、日本国内での流通に必要な各種認証の取得やの関税の適切な処理が担保されます。 ※一部国内に類似商品が出回っている可能性がございます。弊社では他社の類似品に関してもお問い合わせには対応できませんのでご了承ください。 ※本文中に記載させていただいたスケジュールはあくまでプロジェクト公開時点の予定です。応援購入の性質上、配送遅延の恐れがございます。 ※原則として配送遅延に伴る応援購入のキャンセルはできませんが、リターン配送予定月から6か月を超えた場合には希望者に限りキャンセルにて対応させていただきます。
サポーターからの応援コメント
文章のトップに戻る
応援購入する
このプロジェクトはAll in型です。目標金額の達成に関わらず、プロジェクト終了日の2021年12月30日までに支払いを完了した時点で購入が成立します。
【超早割】味や香りを豊かに黄銅ドリッパー刻印なしx1セット

13,600円(税込)
【超早割】味や香りを豊かに黄銅ドリッパー刻印なしx1セット
【一般販売予定価格17,000円の20%OFF】
【セット内容】
黄銅ドリッパーx1
胡桃の木ホルダーx1
黄銅ドリッパー専用ボックスx1
麻紙フィルターx1(100枚入り)
※本製品は刻印なしのドリッパーです。
※ご注文状況、使用部材の供給状況、製造工程上の都合等により出荷時期が遅れる場合があります。
※皆様のご支援により量産効率が向上した場合、正規販売価格が販売予定価格より下がる可能性もございます。
【早割】味や香りを豊かに黄銅ドリッパー刻印なしx1セット

13,900円(税込)
【早割】味や香りを豊かに黄銅ドリッパー刻印なしx1セット
【一般販売予定価格17,000円の18%OFF】
【セット内容】
黄銅ドリッパーx1
胡桃の木ホルダーx1
黄銅ドリッパー専用ボックスx1
麻紙フィルターx1(100枚入り)
※本製品は刻印なしのドリッパーです。
※ご注文状況、使用部材の供給状況、製造工程上の都合等により出荷時期が遅れる場合があります。
※皆様のご支援により量産効率が向上した場合、正規販売価格が販売予定価格より下がる可能性もございます。
【超早割】味や香りを豊かに黄銅ドリッパー刻印ありx1セット

14,200円(税込)
【超早割】味や香りを豊かに黄銅ドリッパー刻印ありx1セット
【一般販売予定価格19,000円の25%OFF】
【セット内容】
黄銅ドリッパーx1
胡桃の木ホルダーx1
黄銅ドリッパー専用ボックスx1
麻紙フィルターx1(100枚入り)
※本製品は藤原道長の和歌が刻まれた刻印ありドリッパーです。
※ご注文状況、使用部材の供給状況、製造工程上の都合等により出荷時期が遅れる場合があります。
※皆様のご支援により量産効率が向上した場合、正規販売価格が販売予定価格より下がる可能性もございます。
【早割】味や香りを豊かに黄銅ドリッパー刻印ありx1セット

14,800円(税込)
【早割】味や香りを豊かに黄銅ドリッパー刻印ありx1セット
【一般販売予定価格19,000円の22%OFF】
【セット内容】
黄銅ドリッパーx1
胡桃の木ホルダーx1
黄銅ドリッパー専用ボックスx1
麻紙フィルターx1(100枚入り)
※本製品は藤原道長の和歌が刻まれた刻印ありドリッパーです。
※ご注文状況、使用部材の供給状況、製造工程上の都合等により出荷時期が遅れる場合があります。
※皆様のご支援により量産効率が向上した場合、正規販売価格が販売予定価格より下がる可能性もございます。
「Makuake(マクアケ)」は、実行者の想いを応援購入によって実現するアタラシイものやサービスのプラットフォームです。このページは、 プロダクトカテゴリの 「黄銅ドリッパーで熱伝達を素早く! 横型のリブが深く豊かな味を出します!」プロジェクト詳細ページです。








